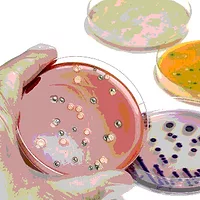

Scientists Detect Low Levels of Listeria in Food Within Eight Hours Using Streamlined Workflow

Image credit: CDC via Unsplash
A new study demonstrates the capability of a streamlined workflow to detect low-level presence of Listeria monocytogenes in food samples within eight hours. The study results were reported in Microbiology Spectrum, a journal of the American Society for Microbiology.
“Using the current laboratory methods, it takes 24–72 hours to identify food samples contaminated with a low level of L. monocytogenes,” said lead study author Min Lin, Ph.D., a research scientist with the Canadian Food Inspection Agency (CFIA). “We conducted this study to develop a streamlined sample-to-answer procedure to shorten the detection of L. monocytogenes in food samples.”
In the new study, researchers designed a sample-to-answer detection workflow by integrating various methods such as culture enrichment, filtration-based sample preprocessing, magnetic separation of target bacteria, and real-time polymerase chain reaction (RT-PCR) into the detection workflow. They evaluated the workflow using ground beef samples artificially contaminated with between one and five cells of L. monocytogenes in 25-gram (g.) analytical units. The workflow allowed the detection of L. monocytogenes within 8 hours in a 25 g. sample unit containing a cell count as low as two L. monocytogenes cells.
“Once the streamlined procedure is evaluated thoroughly and implemented in food microbiology testing laboratories, it will significantly reduce the turnaround time for L. monocytogenes testing in food samples,” Dr. Lin said. “Future research will focus on evaluation of the described workflow for the detection of various L. monocytogenes strains in various food matrices, especially in naturally contaminated foods.”
Dr. Lin hopes the study will stimulate the development of a fully automated system that is capable of completing all the steps in the workflow with little manual operation.
Looking for quick answers on food safety topics?
Try Ask FSM, our new smart AI search tool.
Ask FSM →